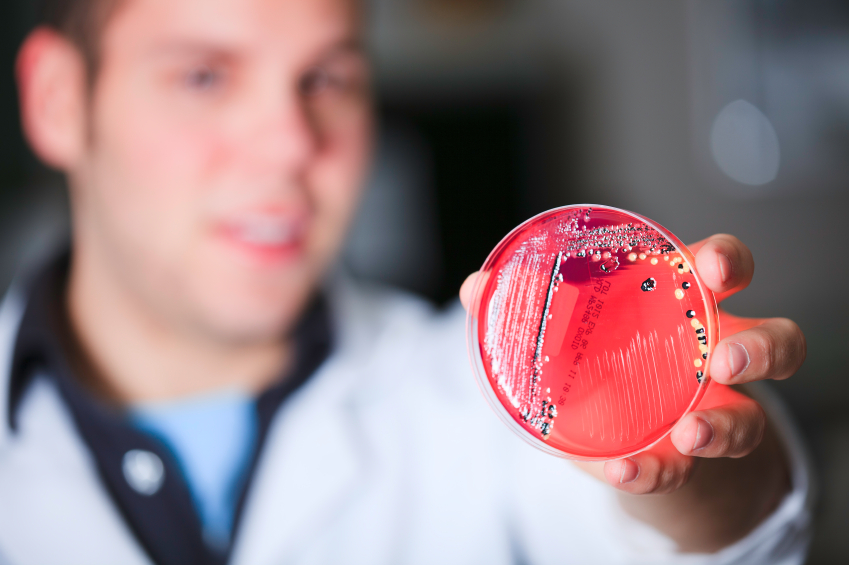

Πώς τα προβιοτικά μπορούν να θεραπεύσουν το διαβήτη
Ένα καλό βακτήριο μπορεί να θεραπεύσει τον διαβήτη.
Ένα καλό βακτήριο ενεργοποιεί την ινσουλίνη του οργανισμού και αναλαμβάνει τον ρόλο του παγκρέατος που νοσεί και αναστέλλει και θεραπεύει τον διαβήτη.
Ο σακχαρώδης διαβήτης έχει δύο τύπους:
Το διαβήτη τύπου Ι ή ινσουλινοεξαρτώμενο, όπου εξαιτιας της καταστροφής των ινσουλινοπαραγωγών κυττάρων του παγκρέατος παράγεται λίγη ή καθόλου ινσουλίνη που καθιστά τα κύτταρα του οργανισμού να προσλαμβάνουν γλυκόζη από το αίμα και να την χρησιμοποιούν σαν ενέργεια και είναι αυτοάνοσο νόσημα που εμφανίζεται σε παιδιά και νέους ενήλικες.
Το διαβήτη τύπου ΙΙ ή μη ινσουλινοεξαρτώμενο που οφείλεται σε ανθυγιεινό τρόπο ζωής και διατροφής και ο οργανισμός δεν μπορεί να χρησιμοποιήσει την παραγόμενη ινσουλίνη από το πάγκρεας αποτελεσματικά και επίσης μειώνεται η παραγωγή της από το πάγκρεας. Ο διαβήτης αυτός αφορά τους ενήλικες και τα παχύσαρκα παιδιά και αποτελεί το 90% των περιπτώσεων διαβήτη.
Ο τρίτος τύπος διαβήτη είναι της κύησης και εμφανίζεται κατά την εγκυμοσύνη σε 3% των κυήσεων και είναι αναστρέψιμη κατάσταση και υποχωρεί μετά τον τοκετό, αλλά ένα 40% των γυναικών που έχουν διαβήτη κύησης θα εμφανίσει διαβήτη τύπου ΙΙ αργότερα στη ζωή της.
Το προβιοτικό αυτό έχει τροποποιηθεί και παράγει πρωτεϊνη GLP-1 (Glucacon-like peptide 1) που μειώνει κατά 30% τα επίπεδα της γλυκόζης στο αίμα μετά από 90 ημέρες.
Όταν τα επιθηλιακά κύτταρα του εντέρου εκτίθενται στην πρωτεϊνη GLP-1 μετατρέπονται σε ινσουλινοπαραγωγά κύτταρα.
Κάθε φορά που κάποιο άτομο καταναλώνει τροφή, το γαστρεντερικό σύστημα και κυρίως, το έντερο παράγει και εκκρίνει ινκρετίνες στην κυκλοφορία του αίματος . Η πρωτεϊνη GLP-1 είναι ινκρετίνη που αυξάνει την ινσουλίνη που παράγεται από το πάγκρεας, μειώνει την έκκριση γλυκαγόνης που εκκρίνεται από τα α κύτταρα του παγκρέατος που αυξάνει τα επίπεδα του σακχάρου μετά το γεύμα και προκαλείται αίσθημα κορεσμού με κατανάλωση λιγότερης τροφής, ενώ παράλληλα μειώνει την έξοδο του περιεχομένου του στομάχου στο έντερο με αποτέλεσμα τη μείωση των επιπέδων γλυκόζης στο αίμα μετά το γεύμα.
Ο λακτοβάκιλλος του ανθρώπινου εντέρου που είναι φιλικό βακτήριο ((Lactobacillus gasseri) όταν τροποποιηθεί κατάλληλα εκκρίνει ινκρετίνη GL-1. Ο λακτοβάκιλλος αυτός μη τροποποιημένος χρησιμοποιείται στην θεραπεία της διάρροιας, του συνδρόμου του ευερέθιστου εντέρου, της νόσου Crohn και άλλων παθήσεων.
Το τροποποιημένο προβιοτικό μεταφέρει το κέντρο ελέγχου της γλυκόζης από το πάγκρεας στο ανώτερο τμήμα του εντέρου.
Για την διαδικασία είναι σημαντικός ο υποδοχέας του GLP-1, καθώς και οι δυο πρωτεϊνες η HNF6 και ΝαF/Α.
Τα καλύτερα προβιοτικά για τη θεραπεία του διαβήτη
Πατήστε, εδώ, για τη θεραπεία του διαβήτη με προβιοτικά
Διαβάστε, επίσης,
Υπάρχουν ωφέλιμοι μικροοργανισμοί;
Όλα όσα πρέπει να ξέρετε για τα βακτήρια
Ποιοι πρέπει να παίρνουν προβιοτικά
Προβιοτικά για καλή στοματική υγιεινή
Θεραπεία ασθενειών ανάλογα με το μικροβίωμα του εντέρου
Ορθομοριακή αποτοξίνωση του γαστρεντερικού συστήματος
Συμπληρώματα διατροφής για τις παθήσεις του πεπτικού
Απώλεια βάρους με το μικροβίωμα του εντέρου
Τα προβιοτικά θεραπεύουν τις νευροψυχιατρικές διαταραχές
Τα προβιοτικά προστατεύουν από τον καρκίνο
Όλες οι ασθένειες ξεκινούν από το έντερο
Η καλύτερη διατροφή για τους διαβητικούς
Ο σακχαρώδης διαβήτης μπορεί να αντιμετωπισθεί με συμπληρώματα διατροφής
Δεν παίζει ρόλο μόνο το φαγητό στην απορρύθμιση του σακχάρου
Συμβουλές για διαβητικούς που κάνουν συχνά ταξίδια
Οι διαβητικοί παθαίνουν υπογλυκαιμία μετά το σεξ
Πότε να κάνετε έλεγχο για διαβήτη
Αυτοκόλλητο για τη μέτρηση σακχάρου στο αίμα
Η καλύτερη αντιμετώπιση της υπεργλυκαιμίας στο διαβήτη
Το σιρόπι από σφένδαμο είναι φάρμακο
Όλες οι ασθένειες ξεκινούν από το έντερο
Τα γαλακτοκομικά με πολλά λιπαρά είναι καλύτερα για την πρόληψη του διαβήτη
Χρήσιμα αφεψήματα για τους διαβητικούς
Τι πρέπει να προσέχουν οι διαβητικοί
Οι κανόνες της διατροφής στον διαβήτη
Οι καλύτεροι μετρητές σακχάρου
Μεταυπογλυκαιμική υπεργλυκαιμία
Τι πρέπει να προσέχουν οι διαβητικοί τους καλοκαιρινούς μήνες
Σύγχρονη αντιμετώπιση του διαβήτη
Οι απαραίτητες βιταμίνες για τους διαβητικούς
Χειρουργική αντιμετώπιση του Σακχαρώδη Διαβήτη
Τι είναι ο γλυκαιμικός δείκτης
Γιατί όσοι έχουν διαβήτη δεν πρέπει να καπνίζουν
Διαβητική Αμφιβληστροειδοπάθεια
Πώς επηρεάζεται η ψυχολογία στον διαβήτη;
Η Β12 για τη διαβητική νευροπάθεια
Το Actos αυξάνει την πιθανότητα για καρκίνο ουροδόχου κύστεως
Το πικρό πεπόνι κάνει καλό στην υγεία
Συμβουλές για να απαλλαγείτε από τις χρόνιες ασθένειες
Η Β12 για τη διαβητική νευροπάθεια
Πώς επηρεάζεται η ψυχολογία στον διαβήτη;
Συμπληρώματα διατροφής για διαβητικούς
Συμπληρώματα διατροφής για ρύθμιση των επιπέδων του σακχάρου
Κόλπο για να απαλλαγείτε από το μεταβολικό σύνδρομο